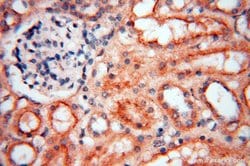
MEF2C Rabbit anti-Human, Mouse, Rat, Polyclonal, Proteintech:Antibodies:Primary

missing translation for 'onlineSavingsMsg'
Learn More
Learn More
MEF2C Rabbit anti-Human, Mouse, Rat, Polyclonal, Proteintech
Rabbit Polyclonal Antibody
1710.33 NOK - 4836.10 NOK
Specifications
| Antigen | MEF2C |
|---|---|
| Concentration | 0.17 mg/mL |
| Applications | Immunohistochemistry (Paraffin), Western Blot |
| Classification | Polyclonal |
| Conjugate | Unconjugated |
| Product Code | Brand | Quantity | Price | Quantity & Availability | |||||
|---|---|---|---|---|---|---|---|---|---|
| Product Code | Brand | Quantity | Price | Quantity & Availability | |||||
|
16858364
|
Proteintech
18291-1-AP-20UL |
20 μL |
1710.33 NOK
20µL |
Please sign in to purchase this item. Need a web account? Register with us today! | |||||
|
16848364
|
Proteintech
18291-1-AP-150UL |
150 μL |
4836.10 NOK
150µL |
Please sign in to purchase this item. Need a web account? Register with us today! | |||||
Description
This antibody can recognize the transcript variant 1, transcript variant 2 and transcript variant 5 of MEF2C.
MEF2C is a transcription activator which binds specifically to the MEF2 element present in the regulatory regions of many muscle-specific genes. Controls cardiac morphogenesis and myogenesis, and is also involved in vascular development. Plays an essential role in hippocampal-dependent learning and memory by suppressing the number of excitatory synapses and thus regulating basal and evoked synaptic transmission. Crucial for normal neuronal development, distribution, and electrical activity in the neocortex. Necessary for proper development of megakaryocytes and platelets and for bone marrow B lymphopoiesis. Required for B-cell survival and proliferation in response to BCR stimulation, efficient IgG1 antibody responses to T-cell-dependent antigens and for normal induction of germinal center B cells. May also be involved in neurogenesis and in the development of cortical architecture. Isoform 3 and isoform 4, which lack the repressor domain, are more active than isoform 1 and isoform 2.Specifications
| MEF2C | |
| Immunohistochemistry (Paraffin), Western Blot | |
| Unconjugated | |
| Rabbit | |
| Human, Mouse, Rat | |
| Q06413, Q8CFN5 | |
| 17260, 4208, 499497 | |
| Peptide | |
| Primary | |
| -20°C | |
| MEF2C |
| 0.17 mg/mL | |
| Polyclonal | |
| Liquid | |
| RUO | |
| PBS with 50% glycerol and 0.02% sodium azide; pH 7.3 | |
| MEF2C, myocyte enhancer factor 2C | |
| Mef2c | |
| IgG | |
| Antigen Affinity Chromatography | |
| Antibody |
Spot an opportunity for improvement?Share a Content Correction
Product Content Correction
Your input is important to us. Please complete this form to provide feedback related to the content on this product.
Product Title